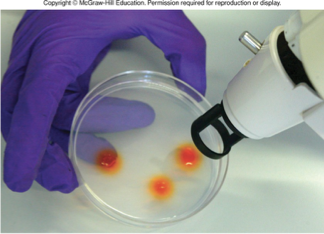
<p>use a gene g*n:</p><p><span>•Coat small metal particles (bullets) with DNA</span></p><p><span>•Shoot DNA bullets at cells</span></p><p><span>•DNA can enter the chloroplast and recombines into the genome.</span></p><p><span>•Transgenic cells identifies using selectable marker.</span></p><p><span>•Transgenic cell cultured to produce a transplastomic</span><span style="font-family: "Tw Cen MT";"> plant.</span></p><p></p>

1/39
Looks like no tags are added yet.
Name | Mastery | Learn | Test | Matching | Spaced | Call with Kai |
|---|
No analytics yet
Send a link to your students to track their progress
four-o-clocks have green or variegated leaves, where did this trait come from?
trait is inherited from the mother (maternal inheritance), due to genes found on the chloroplast genome
mitochondria and chloroplasts are nonnuclear organelles with their own small genomes MEANING
they don’t follow the same pattern and organelle genomes lead to non-Mendelian inheritance
mitochondria (main generators of ATP)
membrane bound cytoplasmic organelles
many in each eukaryotic cell
outer membrane surrounds wrinkled inner membrane
produce energy packets (ATP) trough the Krebs cycle and oxidative phosphorylation

mitochondrial genomes:
some have introns and space between genes; some are circular, others linear
trypanosomes have a kinetoplast - a single mitochondrion with interlocking circles (minicircles and maxicircles) of mtDNA

human mitochondrial genome is…
compact gene arrangement
37 genes encoding tRNAs, rRNAs, and proteins for oxidative phosphorylation
no introns—- only have exons so no need for splicing

mitochondrial genetic code varies in different organisms in which
there are 5 differences between the universal and mitochondrial genetic codes
chloroplasts
membrane bound cytoplasmic organelles in plants
internal structures called thylakoids contain chlorophyll
captures solar energy and store it in chemical bonds of carbohydrates

chloroplast genomes
more than one copy in each chloroplast
compact gene arrangement (do have introns)
circular, linear, and branched forms
have more genes than mitochondria

how to make transgenic chloroplasts by biolistic transformation
use a gene g*n:
•Coat small metal particles (bullets) with DNA
•Shoot DNA bullets at cells
•DNA can enter the chloroplast and recombines into the genome.
•Transgenic cells identifies using selectable marker.
•Transgenic cell cultured to produce a transplastomic plant.
introducing a transgene into cpDNA when transforming the chloroplast genome
altering the properties of commercially important crop plants
for example, can produce herbicide-resistant plants
transgenes will be maternally inherited, so low risk of spreading to other plants via pollen transfer
determine the function of open reading frames
mitochondria and chloroplasts require nuclear gene products to assemble & function
true
functions in mitochondrial electron transport
7 subunits: 3 encoded by mitochondrial genome, 4 by nuclear genes
nuclear genes
cytochrome oxidase c
nuclear genes encode majority of protein required for gene expression in mitochondria and chloroplasts
true
idea that mitochondria and chloroplasts are descended from bacteria that fused with nucleated cells
endosymbiont theory
have their own DNA
like in bacteria, mtDNA & cpDNA are not arranged into nucleosomes
mitochondria use N—formyl methionine and tRNA in translation
inhibitors of bacterial translation block mitochondrial and chloroplast genomes derive from a common ancestor of nonsulfur and cyanobacteria, respectively
organelles must function inside the cell for gene transfer
the organelle gene incorporated into nuclear genome
organelle copy of the gene becomes redundant
changes may make it non-functional
Different organelle genes transferred to nucleus in different lineages leading to organelle diversity
gene transfer likely the driving force for establishing the symbiotic relationship
inheritance of mitochondria and chloroplasts is non-mendelian
true
mutations in organelle genes often produce….
whole-organism phenotypes
may result in slow cell growth leading to small cell colonies or weak tissues
mtDNA mutations
may decrease chlorophyll production leading to a change in leaf color
cpDNA mutations
DNA polymorphisms can be followed by
DNA sequencing
when progeny obtain organelles from both parents
biparental inheritance
when progeny obtain organelles from just one parent
uniparental inheritance
when uniparental inheritance occurs, progeny most often inherit their organelles from the _______
maternal parent
what leads to maternal inheritience
female gamete are mostly larger
zygote receives many female organelles and few parental organelles
Paternal organelles may be actively excluded or destroyed.
Paternal organelles may segregate into non-embryonic cells.
Fertilization may prevent organelles from entering the egg.
Because mtDNA is inherited maternally, it allows exact matches between a child and a maternal grandmother (or other maternal distant relatives); so it can be used to match distantly related ppl. how is it more easily tracked.
bc mtDNA exists in many more copies than nuclear DNA, so it is more easily extracted from ancient samples where DNA might be degraded!
who do ppl say that all mtDNA of every human originated from who lives 200,000 yrs ago
mitochondrial eve
no matter what the father is, progeny had what the maternal had. if she was varigated, progeny was…
variegated or green or white

wildtype cpDNA makes
chlorophyll
mutant cpDNAs have a mutation that
prevents chlorophyll production
cells contain a mixture of organelle genomes
heteroplasmic
cells contain only one type of organelle genome
homoplasmic

mitotic progeny of homoplasmic cells are all homoplasmic
mitotic progeny of herteroplasmic cells can be:
heteroplasmic
homoplasmic wild-type
homoplasmic mutant
uneven distribution of organellar genomes has distinct phenotypic consequences
the relationship between cytoplasmic segregation and variegation is the theshold effect. threshold effect:
a certain fraction of wild-type organelles is sufficient for the normal phenotype
in four-o-clocks, heteroplastic cells make enough chlorophyll to be green

Biparental inheritance of mitochondria in yeast

several diseases of the human nervous system are caused by mutations in the
mitochondrial genome
mutations are passed from mothers to children
symptoms vary due to heteroplasmy

tissues with higher energy requirements are less tolerant of mutant mitochondria
true

tissues with low energy requirements are affected only when the proportion of wild-type mitochondria is greatly reduced
true

oxidative phosphorylation system in the mitochondria generates free radicals, which can damage DNA
accumulation of mtDNA mutations overtime may result in age-related decline in oxidative phosphorylation
evidence in support of mtDNA and aging:
brain cells of people with Alzheimer’s disease (AD) have abnormally low energy metabolism
20% to 35% of mitochondria in brain cells of most AD patients have mutations in cytochrome c oxidase genes, which may explain the low energy metabolism
ooctye nuclear transplantation can sidestep transmission of mitochondria disease
oocyte nuclear transfer is successful in primates
cytoplasmic transfer was legal for a litle; 50 babies were born with 3 biological parents
2017- UK was the first country to legalize a similar “spindle transfer” procedure for parents with known mitochondrial disease